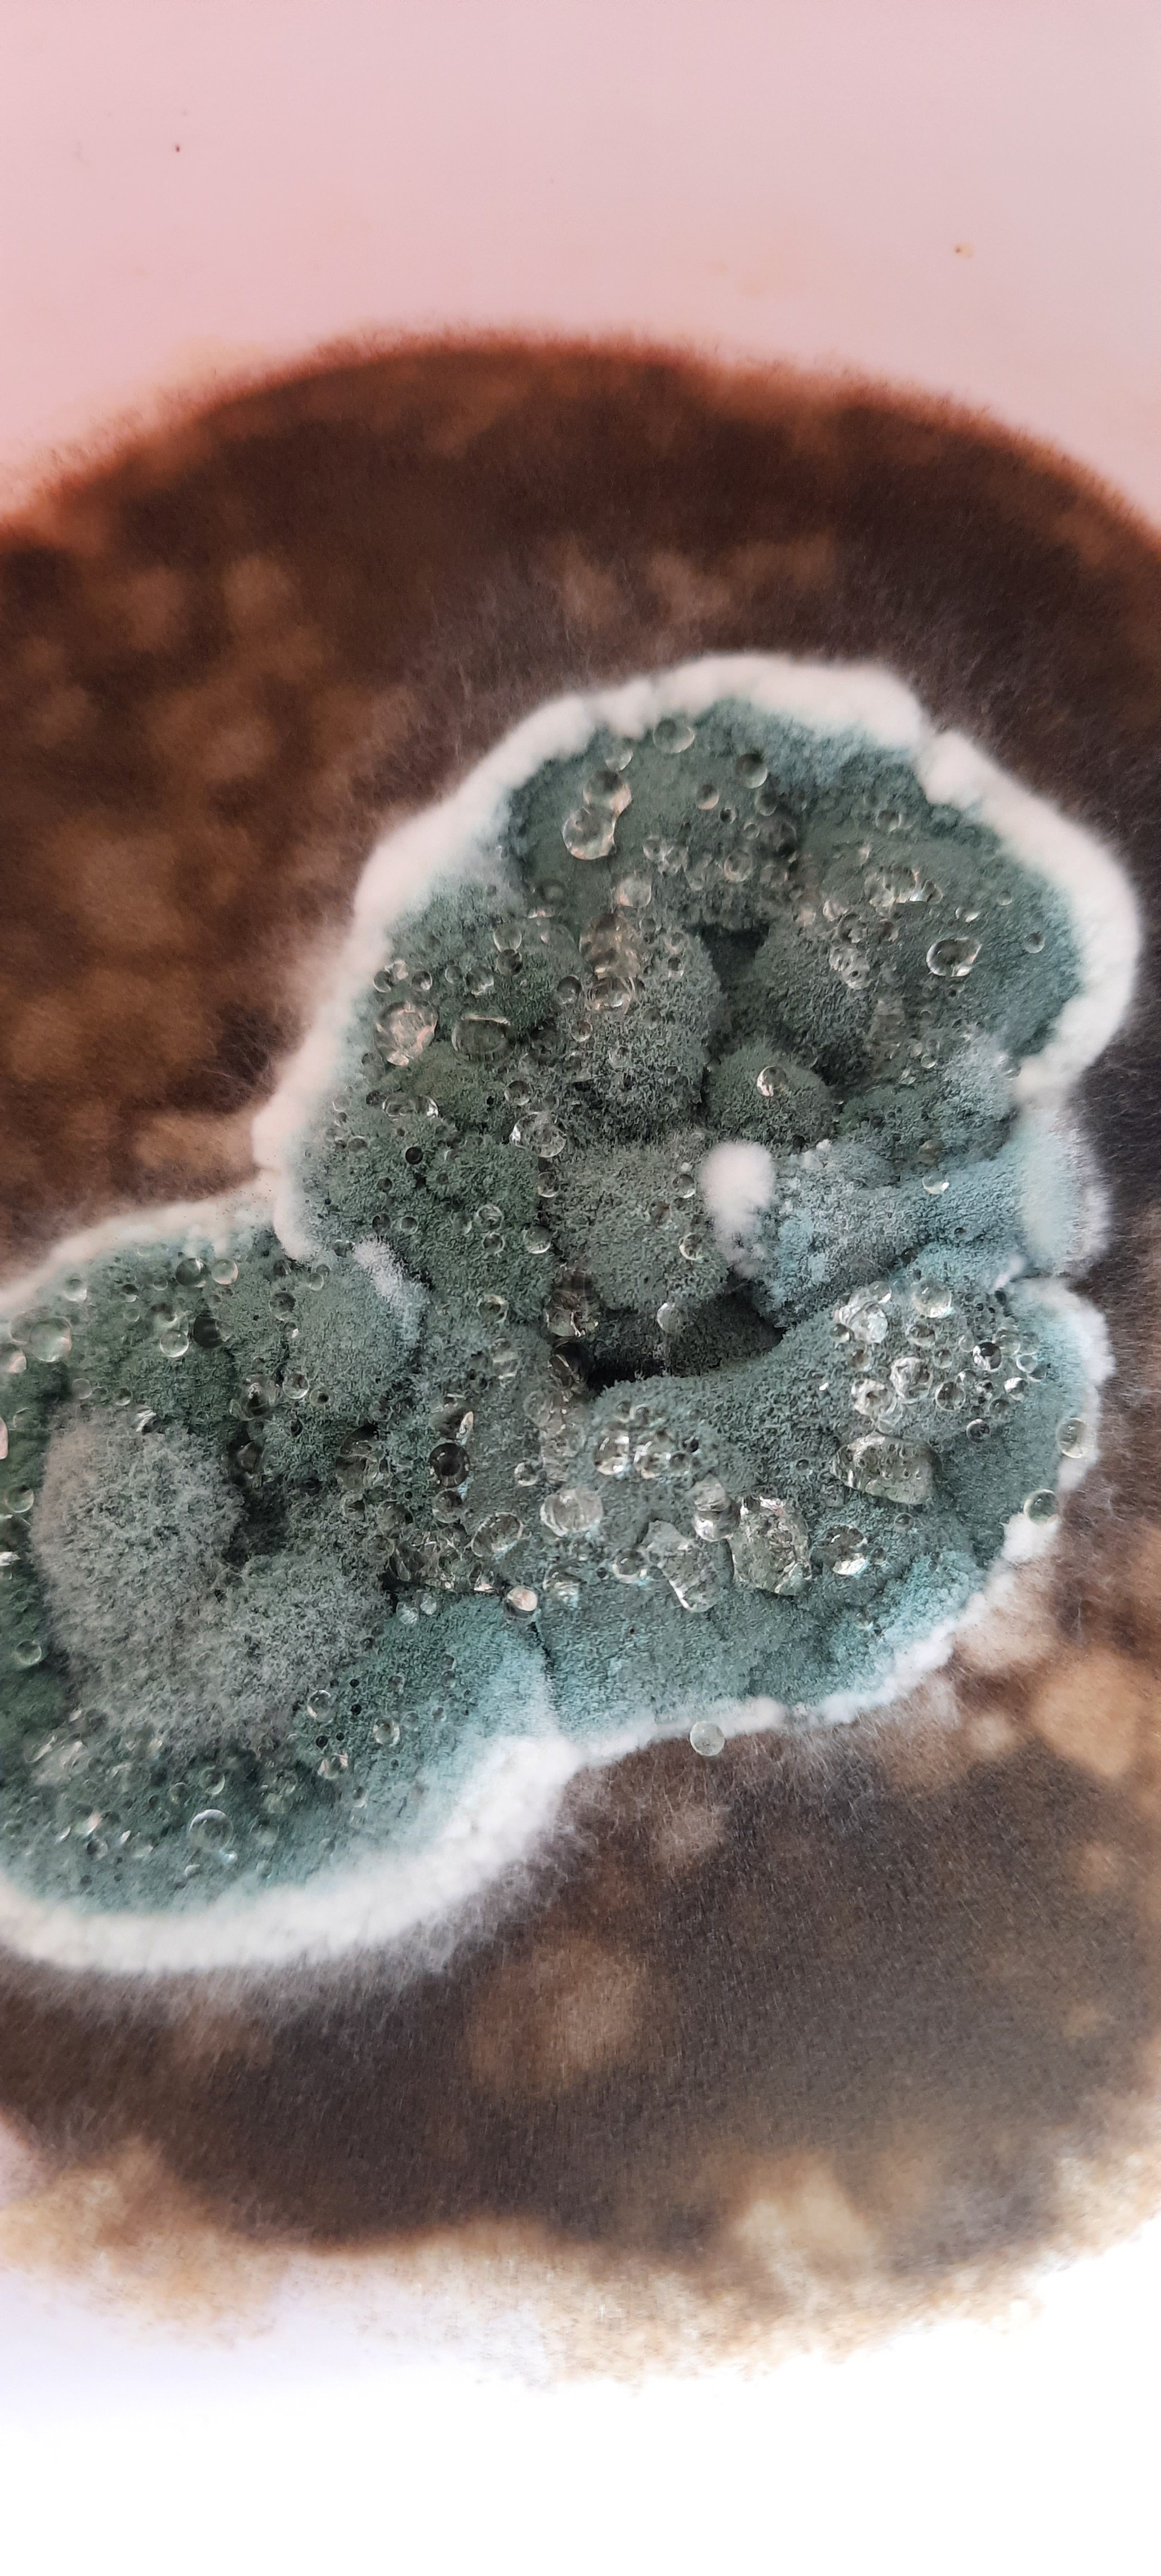

This post may not show me in a good light at all because I have to admit that I have moldy stuff in my fridge and the truth is that I do.
I found some mold in a dish long forgotten, thrust at the back of the fridge ages ago. The mold was funky looking, a bit bland because it didn’t have too many colors but its shape and elements were quite eye-catching.
When you’re trying to get over a rather nasty kind of flu, your mind goes into all sorts of places. Especially since you’re trying to not give it to your family members. This doesn’t necessarily come from a place of altruism because if they got your germs and got sick too, who would take care of you? You’d be a bunch of coughy, sneezy, phlegmy people grunting at each other, walking like zombies instead of being that one person who gets waited on hand and foot because she’s “under the weather”.
Anyhoo, AI art has been bombarding my timeline on all social media platforms I have a presence on and it was only a matter of time before I headed that way myself…so presenting without any further delay…MOLD and its new avatar of MANGA! TADA!!